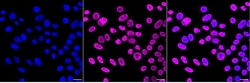
Invitrogen hnRNP K Recombinant Rabbit Monoclonal Antibody (23GB4825), Invitrogen

missing translation for 'onlineSavingsMsg'
Learn More
Learn More
Invitrogen™ hnRNP K Recombinant Rabbit Monoclonal Antibody (23GB4825), Invitrogen™
Rabbit Recombinant Monoclonal Antibody
Brand: Invitrogen™ MA553813
This item is not returnable.
View return policy
Description
This gene belongs to the subfamily of ubiquitously expressed heterogeneous nuclear ribonucleoproteins (hnRNPs). The hnRNPs are RNA binding proteins and they complex with heterogeneous nuclear RNA (hnRNA). These proteins are associated with pre-mRNAs in the nucleus and appear to influence pre-mRNA processing and other aspects of mRNA metabolism and transport. While all of the hnRNPs are present in the nucleus, some seem to shuttle between the nucleus and the cytoplasm. The hnRNP proteins have distinct nucleic acid binding properties. The protein encoded by this gene is located in the nucleoplasm and has three repeats of KH domains that binds to RNAs. It is distinct among other hnRNP proteins in its binding preference; it binds tenaciously to poly(C). This protein is also thought to have a role during cell cycle progression. Several alternatively spliced transcript variants have been described for this gene, however, not all of them are fully characterized.
Specifications
| hnRNP K | |
| Recombinant Monoclonal | |
| Unconjugated | |
| HNRNPK | |
| AUKS; CSBP; dC stretch-binding protein; dC-stretch binding protein; FLJ41122; heterogeneous nuclear ribonucleoprotein K; heterogeneous nuclear ribonucleoprotein K S homeolog; hnRNP K; Hnrnpk; hnRNP-K protein; hnrnpk.S; hnrpk; KBBP; NOVA; RP11-575L7.1; transformation upregulated nuclear protein; Transformation up-regulated nuclear protein; TUNP; XELAEV_18010151mg | |
| Rabbit | |
| Affinity chromatography | |
| RUO | |
| 117282, 15387, 3190 | |
| -20°C | |
| Liquid |
| Flow Cytometry, Western Blot, Immunocytochemistry | |
| 23GB4825 | |
| PBS with 50% glycerol and 0.02% sodium azide; pH 7.4 | |
| P61978, P61979, P61980 | |
| HNRNPK | |
| A synthesized peptide derived from human hnRNP K (1-53AA). | |
| 20 μL | |
| Primary | |
| Human, Mouse, Rat | |
| Antibody | |
| IgG |
Product Content Correction
Your input is important to us. Please complete this form to provide feedback related to the content on this product.
Product Title
Spot an opportunity for improvement?Share a Content Correction